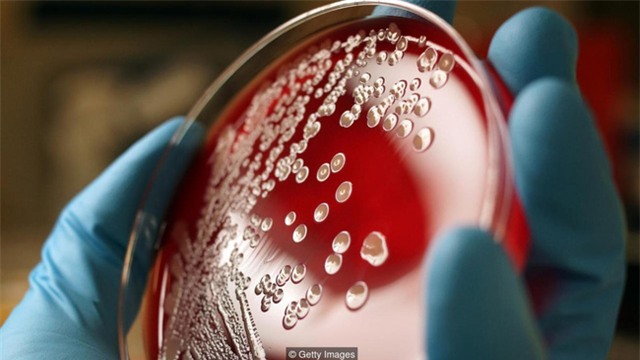

Những nghiên cứu mới nhất cho thấy rằng, việc rửa tay không thể làm tay sạch hoàn toàn hay 99,9% như các quảng cáo.
Rửa tay là một biện pháp rất tốt để ngăn ngừa sự lây lan của các loại vi trùng. Nhưng chúng ta có thể thấy dù rửa tay và khử trùng tay kỹ đến đâu, những vị bác sĩ hay người bán thực phẩm vẫn phải sử dụng găng tay trong quá trình làm việc.
Lý do là bởi việc rửa tay chỉ giúp con người loại bỏ vi khuẩn trên da tay, còn những loại vi khuẩn trú ngụ bên dưới móng tay là "bất khả xâm phạm".
Móng tay và sự thật... kinh dị

Đến cuối những năm 1980, các nhà khoa học mới tiến hành "mổ xẻ" nghiên cứu những gì có ở bên dưới móng tay con người.
Và trong một thí nghiệm vào năm 1988, bộ ba nhà khoa học đến từ khoa Da liễu của ĐH Pennsylvania (Mỹ) thực hiện một nghiên cứu trên móng tay của 26 tình nguyện viên.

Kết quả nghiên cứu cho thấy, ở giữa lớp móng tay của con người và phần thịt ngón tay tồn tại một khoảng không nhỏ gọi là subungual. Đây là địa điểm lý tưởng để "chứa chấp" các loài vi khuẩn có hại cho con người. Số lượng thì... lên tới hàng trăm ngàn loài.
Sở dĩ khu vực subungual được coi là địa điểm phù hợp cho các vi khuẩn tập hợp là bởi nơi đây hội tụ đầy đủ yếu tố giúp chúng phát triển. Lớp móng tay có vai trò như một tấm khiên bảo vệ vi khuẩn khỏi các tác động vật lý bên ngoài, và ngoài ra còn giúp duy trì độ ẩm.
Móng tay tự nhiên vẫn là nhất
Một số nghiên cứu còn cho biết vi khuẩn phát triển và sinh sôi không chỉ ở móng tay tự nhiên mà còn ở móng tay giả hoặc móng tay được sơn. Thậm chí, lượng vi khuẩn trên các loại móng này có số lượng lớn hơn rất nhiều so với trên móng tay tự nhiên.
Vào năm 1989, nước Mỹ xôn xao về một chủ đề, đó là việc có cho phép y tá được phép sơn móng tay trước khi chăm sóc bệnh nhân hay không.

Có 56 y tá được mời thí nghiệm, và kết quả cho thấy lượng vi khuẩn trên móng tay của họ nhiều hơn hẳn so với số y tá để móng tay tự nhiên, kể cả trước hay sau khi rửa tay.
Tuy vậy, chỉ vi khuẩn trên đầu ngón tay họ là nhiều hơn, nên điều này không có nghĩa là các y tá có thể truyền nhiều vi khuẩn vào người bệnh hơn. Điều này chỉ đúng trong trường hợp các y tá sơn móng tay thôi.
Theo nghiên cứu từ năm 2002, những người đeo móng tay giả cũng có xu hướng rửa tay qua loa hơn mà chính bản thân họ cũng không biết, khiến cho lượng vi khuẩn tồn đọng trên tay là tương đối lớn.

Thêm vào đó, móng tay giả của y tá cũng bị đem ra chỉ trích trong suốt thời gian đầu thế kỷ 21. Những chiếc móng tay giả chứa một lượng vi khuẩn cũng rất lớn và thậm chí có thể làm rách những chiếc găng tay dùng một lần trong bệnh viện.
Mỗi năm có từ 2 đến 3 triệu người chết do tiêu chảy, và tác nhân gây bệnh có thể đến ngay từ móng tay của bạn.
Vì vậy, các chuyên gia cũng khuyên rằng chúng ta chỉ nên giữ móng tay ngắn và sạch. Ngoài ra để cẩn thận hơn bạn cũng nên chuẩn bị một chiếc bàn chải để cọ rửa móng tay khi rửa tay với xà phòng.
Theo Trí thức trẻ